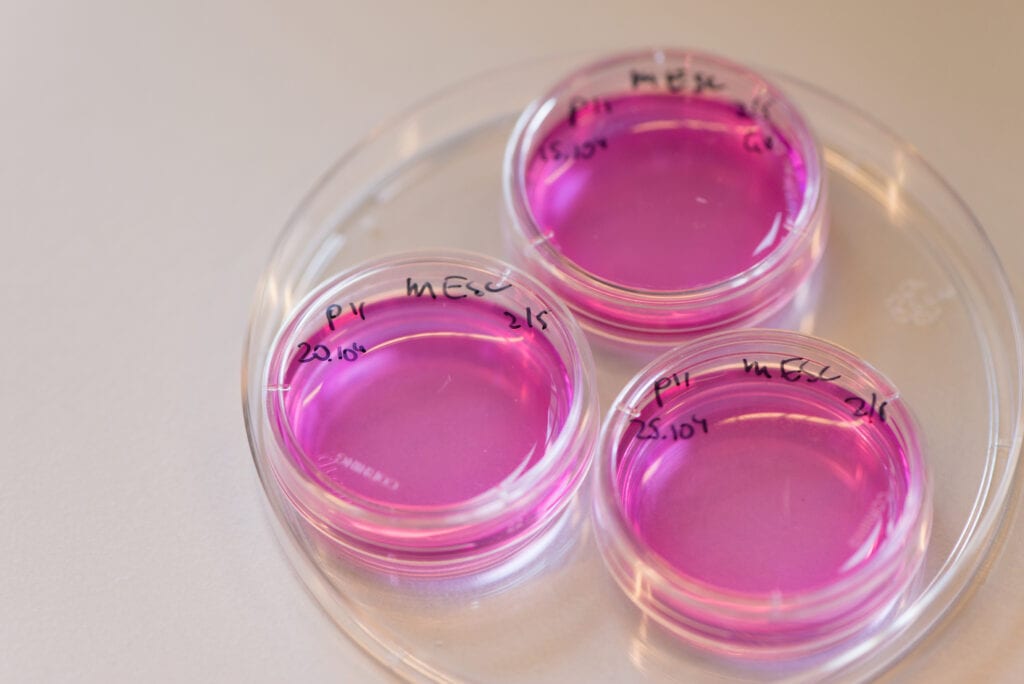
petrischaaltje proefdiervrij

Welkom bij Drijfveren. Hier vertellen Proefdiervrij-onderzoekers wat hen motiveert om tegen de stroming in te gaan. Dit keer is het aan Aldert Piersma. Hij doet onderzoek naar de schadelijkheid van chemische stoffen voor ongeboren baby’s, zonder hier proefdieren voor te gebruiken.
Aldert: “Bij het RIVM werk ik samen met een aantal collega’s aan de preventie van aangeboren afwijkingen, die door blootstelling aan stoffen en geneesmiddelen kunnen ontstaan. Normaal worden hier veel proefdieren voor gebruikt, dus de zoektocht naar proefdiervrije methoden is dan ook van groot belang.”
“Om te onderzoeken welk effect chemische stoffen kunnen hebben op de ontwikkeling van een embryo, werken wij met gekweekte menselijke stamcellen. Deze stamcellen groeien in de kweek uit tot bijvoorbeeld spiercellen, zenuwcellen of botcellen; zoals dat ook in een embryo gebeurt.
Deze processen kunnen verstoord worden door een schadelijke stof, waardoor er een aangeboren afwijking kan ontstaan. Met ons onderzoek kunnen wij zo een schadelijk effect al in een vroeg stadium herkennen.
Onze hoop is dat op den duur proefdieren in dit onderzoek overbodig worden, door de ontwikkeling en implementatie van proefdiervrije testen in celkweken.”

Steeds meer proefdiervrij onderzoek mogelijk
Aldert: “Aan de ene kant ben ik een voorstander van het beperken van proefdiergebruik waar dat mogelijk is. Onnodig leed toebrengen aan een dier is onethisch. Het doen van een dierproef vraagt elke keer weer een goede afweging. We moeten daarom het nu nog noodzakelijke proefdiergebruik terugdringen en werken aan proefdiervrije onderzoeksmodellen.
“Proefdieren zijn geen mensen: de voorspellingen uit dierproeven zijn niet perfect.”
Gelukkig neemt de kennis van biologische processen – en hoe deze verstoord kunnen worden door chemische stoffen – continu toe. Die kennis, gecombineerd met technologische ontwikkelingen, maakt het steeds vaker mogelijk om zonder proefdieren doelgerichter onderzoek voor mensen te doen. En daar draag ik graag aan bij.”
Fijne samenwerking
Aldert: “Wat ik fijn vind aan een samenwerkingspartner als jullie, is dat jullie oog hebben voor zowel de ethische als de wetenschappelijke uitdagingen in het vak. Daarin zoeken jullie voortdurend een goede balans.
Maar ik ben vooral onder de indruk van het enthousiasme waarmee jullie visie wordt uitgedragen. Het is bijzonder motiverend om te zien hoe mensen zich zorgen maken over proefdieren en hun welzijn.”
Hoe zien de volgende 10 jaar er uit?
Aldert: “Ik denk dat over 10 jaar de risicoschatting van chemische stoffen meer gebaseerd zal zijn op menselijke data. Ook zal er meer gebruik gemaakt worden van celkweken met menselijke cellen. Die gegevens zullen in computermodellen worden samengebracht om risico’s voor de mens in te schatten.
Wij bewegen daarom doelbewust die kant op, door te werken aan betere celkweken en aan computermodellen voor biologische processen en risicoschatting.”
